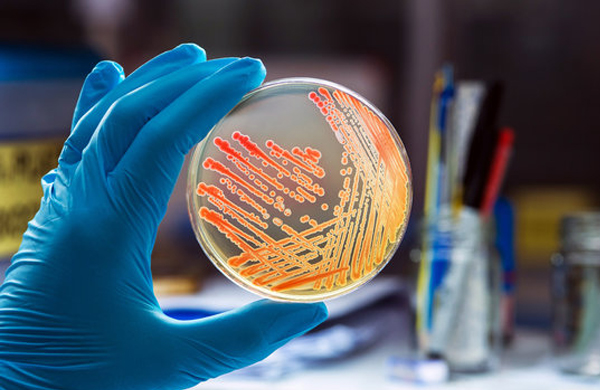

Thought Of the Day
Quotes
Do whatever you can to do with no fear of doing anything
-Subramaniya Bharathiyar
Events
Department
About College
Sri Venkateshwara College of Arts and Science, located in Peravurani, Thanjavur District, was established in 1998 by the Visionary Trust, Peravurani. Originally a co-educational institution, it transitioned into a women's college in 2010-2011, providing excellent educational opportunities for women. Affiliated with Bharathidasan University and recognized by the University Grants Commission (UGC) under sections 2(F) and 12(B) of the UGC Act, 1956, the college aims to offer quality education with discipline to the daughters of underprivileged small marginal farmers and fishermen in and around Peravurani.
In its 24 years of existence, the college has grown phenomenally, offering 15 full-fledged undergraduate and 9 postgraduate programs, along with M.Phil courses in Commerce and Microbiology. With a student strength of 1500 and a dedicated faculty of 75 members, Sri Venkateshwara College has produced 100 university ranks, reflecting its commitment to academic excellence.
Why Choose Us?
- Quality Education: We offer a wide range of undergraduate, postgraduate, and M.Phil programs with a focus on academic excellence.
- Experienced Faculty: Our dedicated and qualified faculty members are committed to providing the best education and guidance to our students.
- Holistic Development: We focus on the overall development of our students, including academic, social, physical, moral, spiritual, and aesthetic aspects.
- Recognition and Grants: Our college is recognized by the UGC and eligible for grants, ensuring continuous improvement and support.
- State-of-the-Art Facilities: Our campus includes modern infrastructure, research labs, a library, playgrounds, and an auditorium in a peaceful environment.







 NEW SESSION ADMISSION OPEN 2024-2025
NEW SESSION ADMISSION OPEN 2024-2025